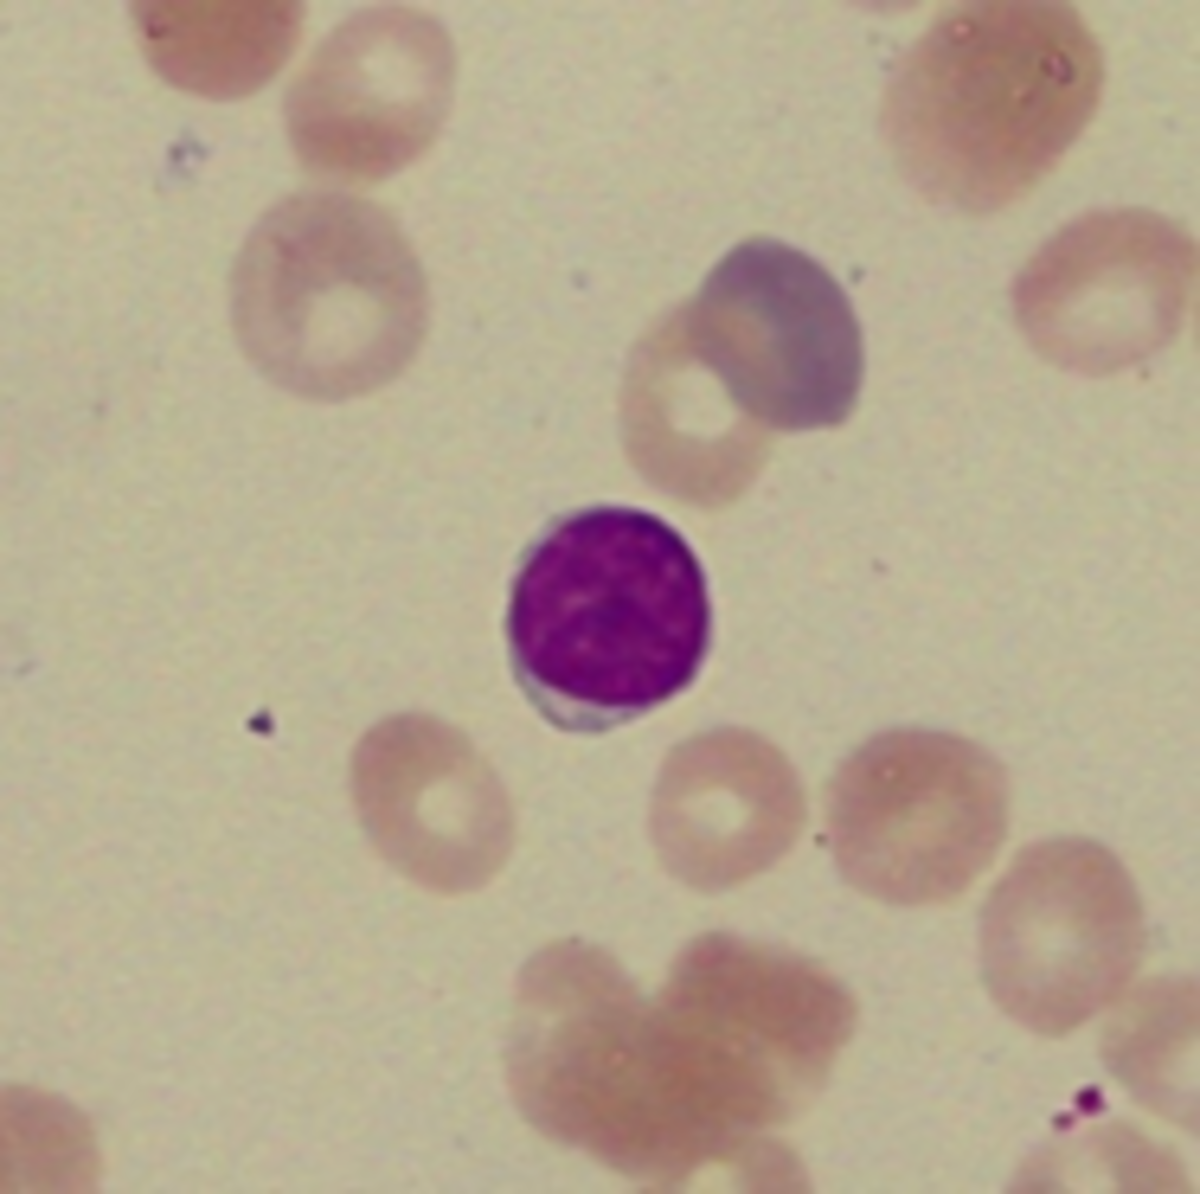
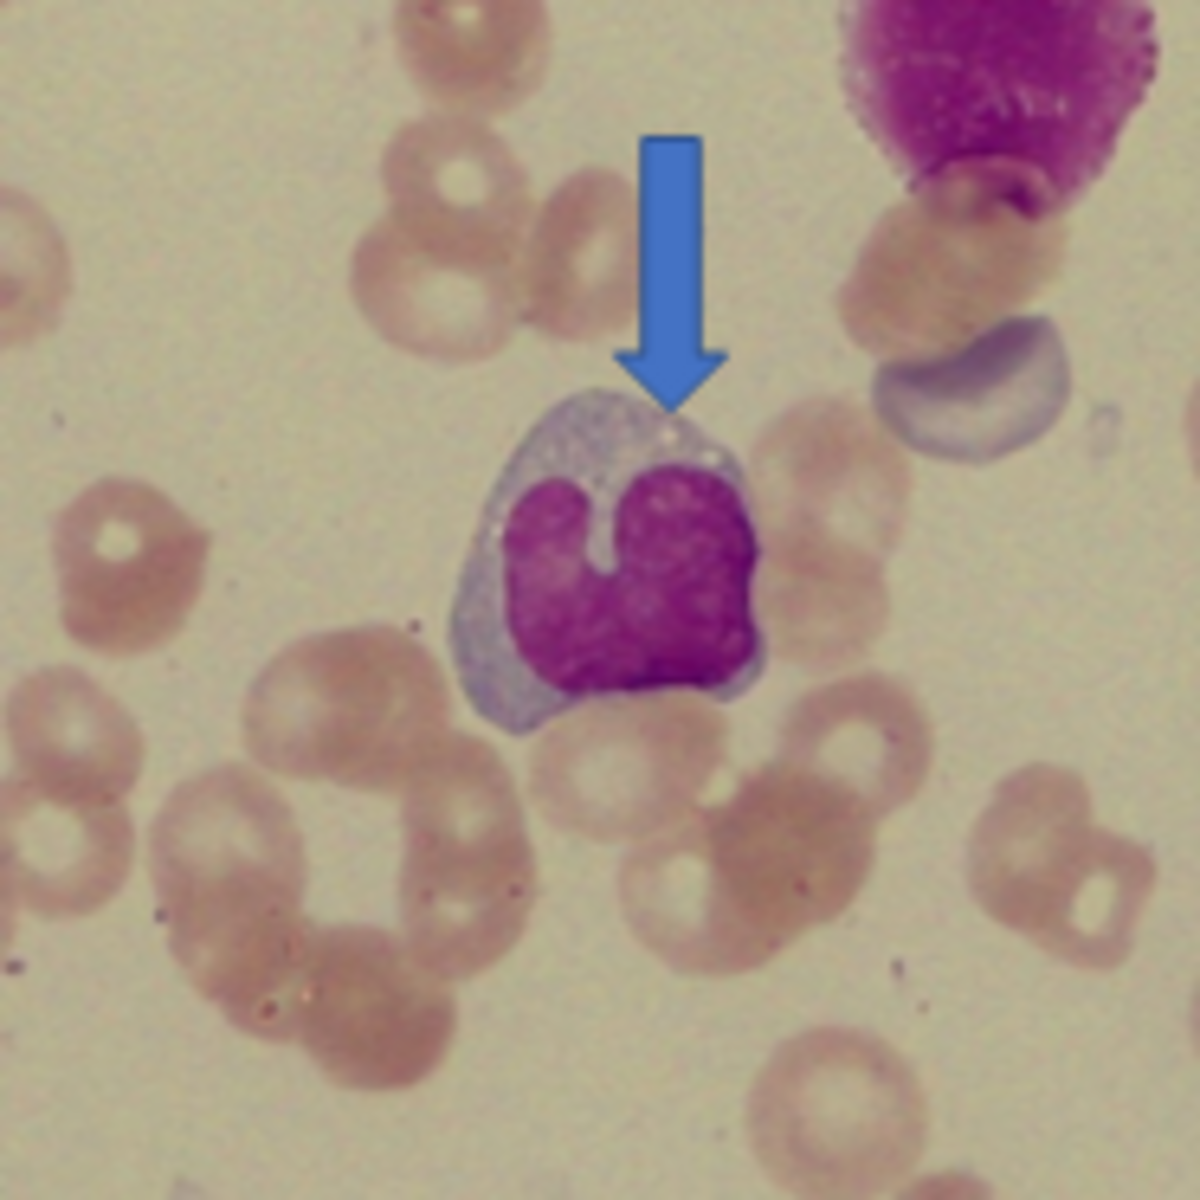
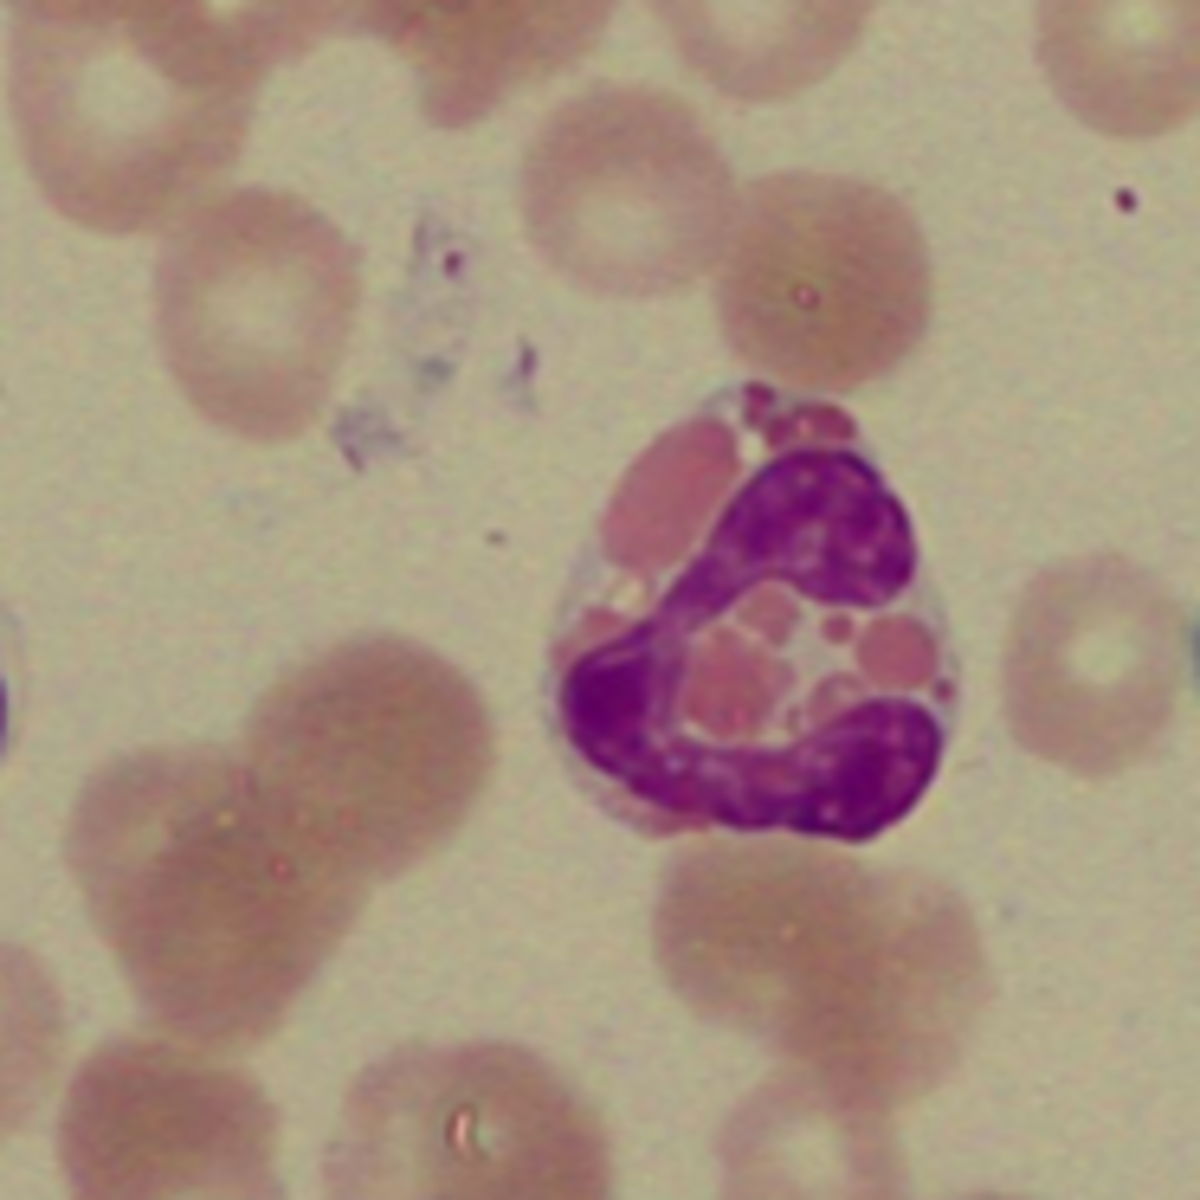
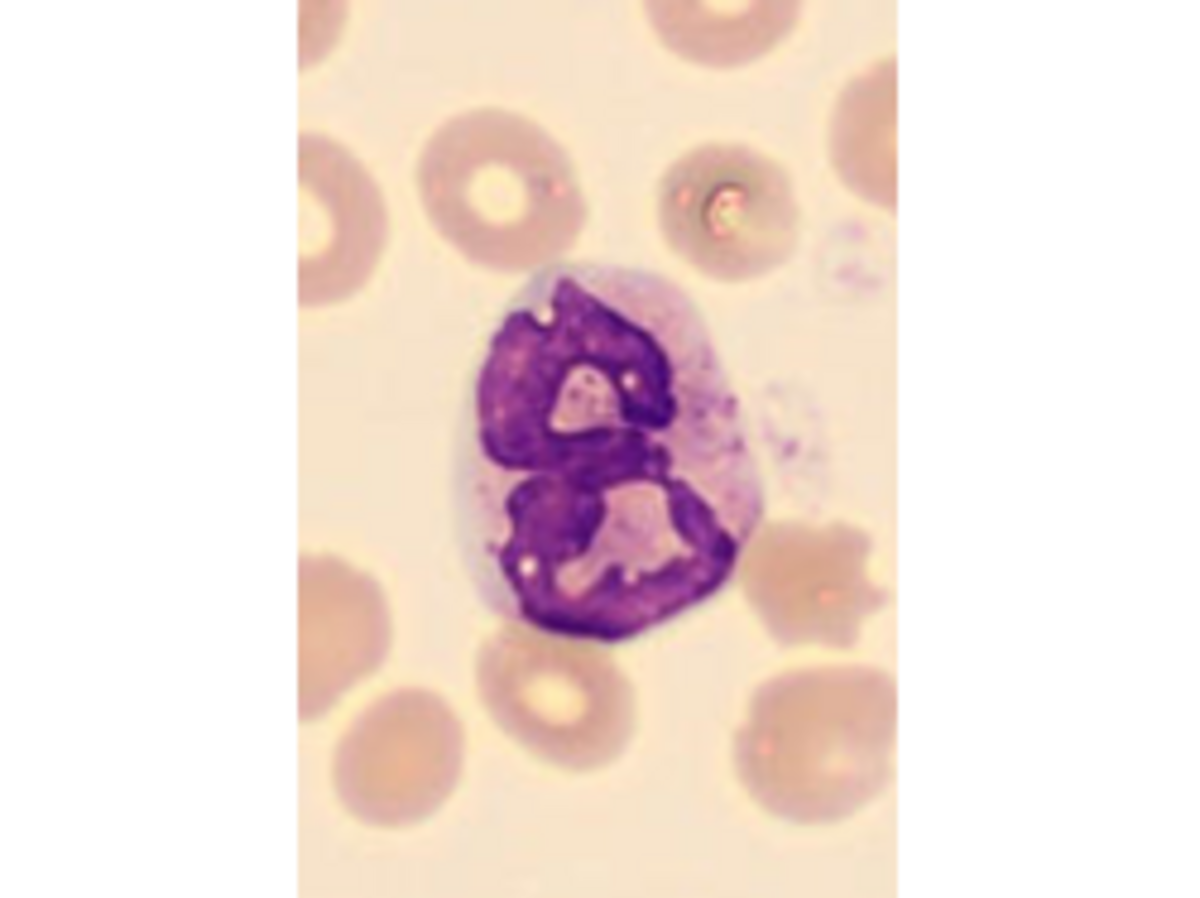
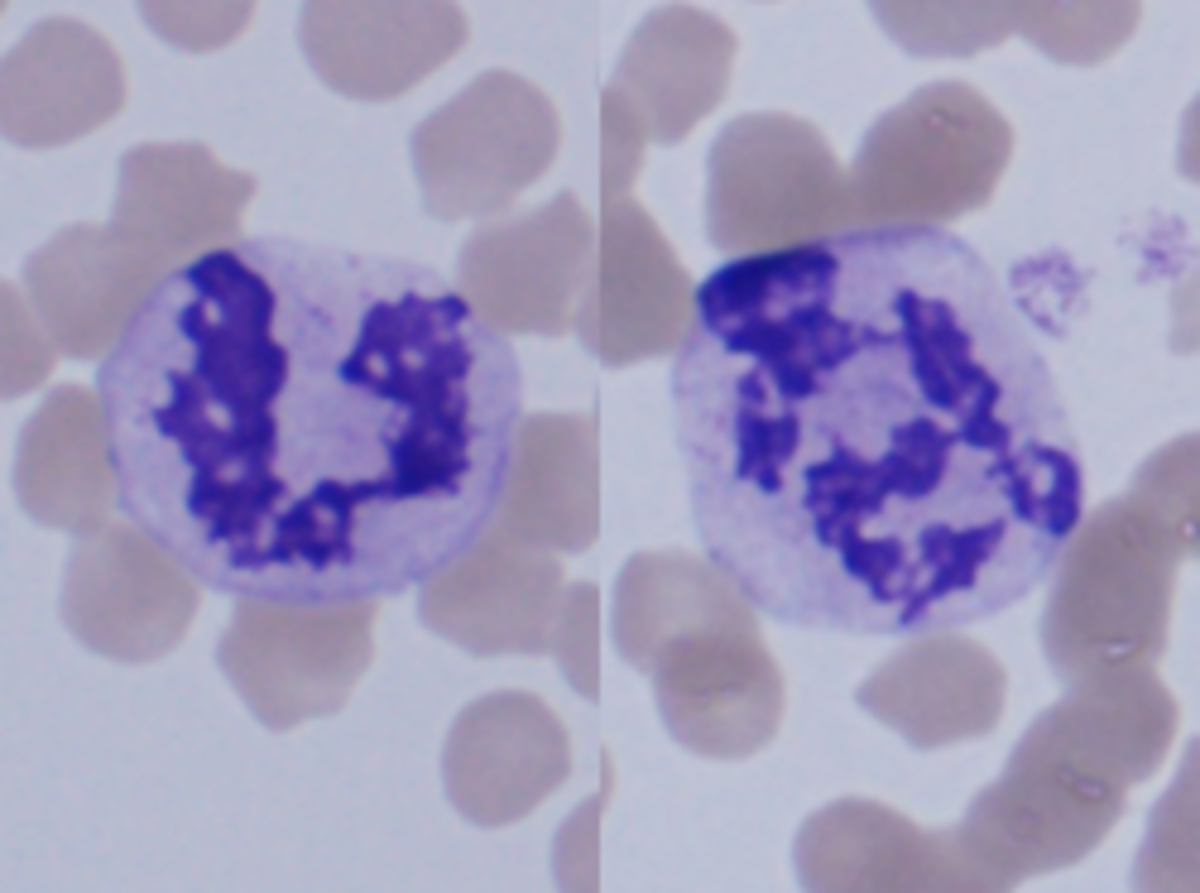
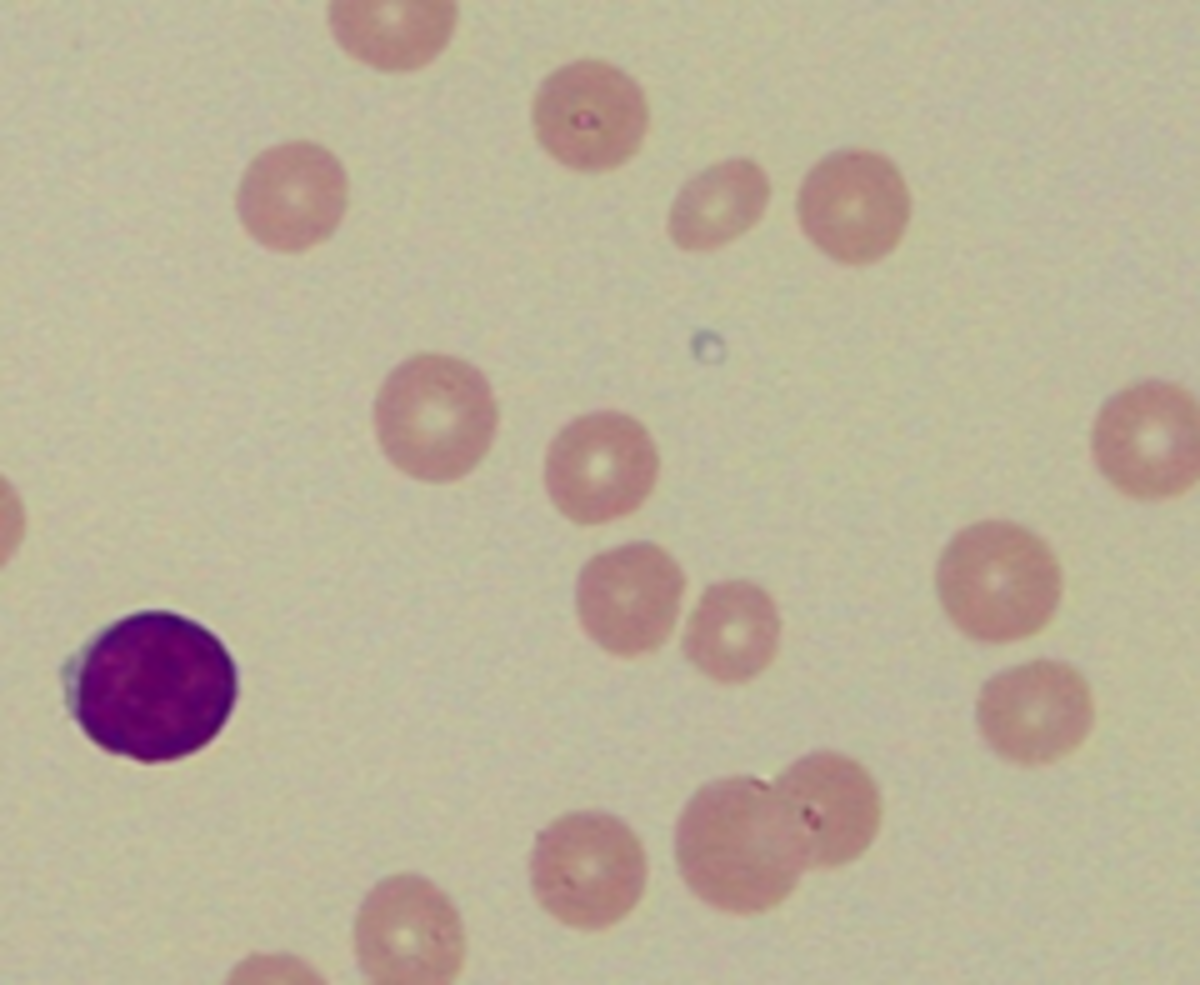

対談企画
前回は、「血液塗抹標本をつくる」と題して、実際に、犬、猫の血液を使って、血液塗抹標本の作製・観察を行いながら、それぞれの立場からお話しいただきました。今回は、犬、猫の代表的な血液細胞について、その特徴をお話しいただきます。
対談者プロフィール
根尾櫻子
麻布大学獣医学部獣医学科
臨床診断学研究室講師
2001年 麻布大学獣医学部獣医学科卒業
2005年 麻布大学大学院獣医学研究科博士課程(獣医学専攻)修了
2008年 University of Pennsylvania(Veterinary Clinical Pathology, Residency Program)修了
2008年 麻布大学獣医学部内科学第2研究室 助教
2010年 米国獣医病理学臨床病理専門医{Diplomate ACVP (Clinical pathologist)}取得
2018年 麻布大学獣医学部臨床診断学研究室 講師
現在に至る
湯浅宗一
株式会社堀場製作所
バイオヘルスケア本部学術顧問
1973年 京都府立医科大学附属病院 臨床検査部 入職
1995年 緒方富雄賞受賞
2000年 京都府立医科大学附属病院 臨床検査部 技師長
2000年 文部大臣表彰
2011年 京都府立医科大学附属病院 臨床検査部 退職
2012年 株式会社堀場製作所 在籍中
2012年 京都府立医科大学 先端検査機器開発講座 在籍中
2015年 瑞宝双光章受章
根尾櫻子先生(以下、根尾):ヒトでは細胞質内に好中性顆粒が観察できることから、好中球と呼ばれますが、犬や猫では顆粒はあまり顕著ではありません。若い細胞では核が桿状を示し桿状核球と呼ばれますが、次第に核にくびれが生じ、分葉核球となります。くびれの判断は「核の幅の最大直径の1/2以下の幅の部分があれば、くびれとする*1」とされています。
湯浅宗一先生(以下、湯浅):基本的に動物と同じですが、ヒトでの桿状核球と分葉核球についての判断は以下の様に細かく決まっています。*2
・桿状核球:核の長径と短径の比が3:1以上、かつ、核の最小幅(a)と核の最大幅(b)の1/3以上で長い曲がった核 | ![]() |
健常者の末梢血液中では60%程度の割合で見られます。
図1 分葉核好中球(犬、正常)
図3 桿状核好中球(犬、正常)
図2 分葉核好中球(猫、正常)
図4 桿状核好中球(猫、正常)
*1:久末正晴,犬と猫の血液学 キソのキソからやさしく解説,インターズー,2013
*2:新しい好中球目視区分法(日本検査血液学会、日本臨床衛生検査技師会標準化合同委員会(2016))
根尾:赤血球の1.5倍程度の大きさです。核が大きく、メイ・ギムザ染色やライト・ギムザ染色では濃い紫色に染まります。細胞質は狭く、核の周囲が明るく見える「核周明庭」と呼ばれる所見が観察されます。基本的には丸い形をしていますが、異型リンパ球など形の異なるものもあります。
湯浅:基本的に動物と同じです。健常者の末梢血液中では30%程度の割合で見られます。「核周明庭」はBリンパ球が分化した形質細胞で見られます。
図5 リンパ球(犬、中央)
図6 リンパ球(猫、中央)
根尾:白血球の中で最も大きな細胞です。核は深く切れ込みが入っている場合や腎臓型や馬蹄型など様々な形態をとり、核内部はクロマチン凝集が少なく繊細です。細胞質は、メイ・ギムザ染色やライト・ギムザ染色では灰青色に染まり、空胞(図7、矢印部分)が見られることもあります。
湯浅:基本的に動物と同じです。細胞質にはリンパ球に比較して細かい顆粒が見られます。健常者の末梢血液中では5%程度の割合で見られます。
図7 単球(犬、中央)
図8 単球(猫、中央)
根尾:細胞質全体に好酸性の顆粒がみられる細胞です。メイ・ギムザ染色やライト・ギムザ染色では顆粒は桃色~橙黄色に染まります。核は好中球と同様に、経時的にくびれが生じ、分葉核となります。犬では大きめの顆粒が見られ(図9)、猫では均一な細かい顆粒が見られます(図10)。
湯浅:基本的に動物と同じです。顆粒の大きさに個人差はなく、ネコに見られるような好酸球顆粒が見られるのが通常です。健常者の末梢血液中では3%程度の割合で見られます。
図9 好酸球(犬、中央)
図10 好酸球(猫、中央)
根尾:塩基性の色素で暗紫色に染色される顆粒が細胞質に存在する顆粒球です。犬や猫では存在比率が0~0.7%程度と非常に低く、目視では見つけるのが難しい細胞です。顆粒はメタノールに溶けやすい性質を持っています。犬が赤紫色に近い顆粒であるのに対し(図11)、猫の顆粒は青みがかったラベンダー色をしています(図12)。犬、猫ともに核上に空胞が見られるのも特徴の一つです。
湯浅:基本的に動物と同じで、人においても非常に少ない細胞です。顆粒の個人差はみられず、紫色の大型好塩基性顆粒が見られます。
図11 犬の好塩基球
図12 猫の好塩基球
根尾:核のない細胞で、中央のくぼんでいる部分には、ヘモグロビンが少ないため、白く見えます。この部分は、セントラルペーラーと呼ばれます。猫の赤血球は、犬の赤血球よりサイズは小さく、球状に近いため、犬ほどセントラルペーラーが広くないという特徴があります。
湯浅:基本的に動物と同じですが、名称はセントラルパーラーと呼ばれ、大きさの個人差はなく健常人では直径は8μm程度です。病気によって特徴的な大きさになることがあり、例えば鉄欠乏性貧血では小さい赤血球、反対に巨赤芽球性貧血では大きな赤血球がみられます。
図13 赤血球(犬、正常)
図14 赤血球(猫、正常)
根尾:血小板は、巨核球にて形成・放出される細胞で、血液凝固を担います。犬と猫では、その大きさに特徴があり、犬の正常血小板は、赤血球より小さいが、猫の血小板は、正常でも、赤血球より大きい場合があります。
キャバリア・キング・チャールズ・スパニエルのように、犬種によっては、正常な場合でも、大型血小板が観察されることがあります。
湯浅:健常人では血小板の大きさは直径2-4μm程度で、個人差はありません。
EDTA加採血管で採取した血液では、血小板が凝集し、実際よりも少なく計測される(EDTA依存性偽性血小板減少症)ことがあり、注意が必要です。
図15 血小板(犬、正常)
図16 血小板(猫、正常)
2023年4月掲載
※内容は掲載時点の知見であり、最新情報とは異なる場合もございます。